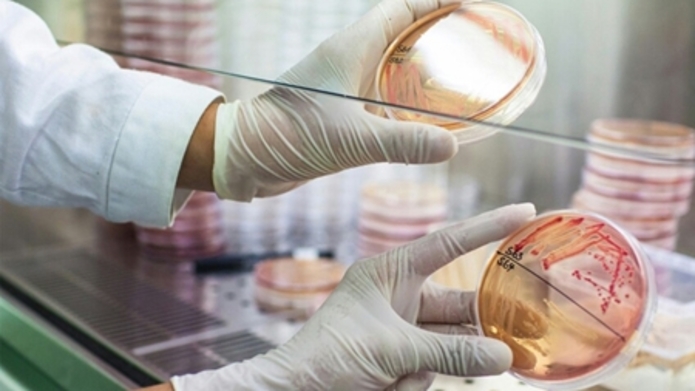

محصولات زیستی ایرانساخت به شرق آفریقا رسید
به گزارش« نبض فناوری» این کار با حمایت معاونت علمی و فناوری ریاست جمهوری و با همکاری شرکت گسترش صادرات داتیس پارس اجرایی و دفتر تخصصی صادرات محصولات زیستفناورانه ایرانی در منطقه شرق آفریقا ایجاد شد. محل این دفتر در کشور اوگاندا و در شهر کامپالا مرکز این کشور است.
در حال حاضر این دفتر به صورت تخصصی در زمینه «انواع نهادههای کشاورزی»، «محصولات پروبیوتیک انسانی و دامی»، «انواع مکملهای غذایی دامی»، «محصولات دارویی»، «کیتهای تشخیصی» و «تجهیزات» فعالیت میکند.
برای اجرایی شدن این کار در مرحله نخست از طریق ایجاد یک مزرعه نمونه به وسعت 10 هکتار و با استفاده از انواع کود و بذر 8 شرکت ایرانی، بازاریابی و تست محصولات شرکتهای دانشبنیان در حال پیگیری و انجام است.
در مرحله بعد، محصولات 10 شرکت دیگر با محوریت «مکملهای دامی» و «پروبیوتیکهای انسانی» انتخاب شده است تا پس از بازاریابی و تست محصولات، به بازار این منطقه وارد شود.
ایجاد دفاتر تخصصی خارجی در دیگر کشورها اقدامی است که ستاد توسعه زیست فناوری معاونت علمی و فناوری ریاست جمهوری با هدف توسعه صادرات محصولات دانشبنیان زیستی در بازارهای بینالمللی اجرایی کرده است. قرار بر این است که تا پایان سال 1400 دفاتر تخصصی در دیگر کشورها نیز ایجاد شود.
اوگاندا با داشتن ذخائر ارزشمند طبیعی، اراضی بسیار حاصلخیز، ثبات قابل ملاحظه سیاسی و رشد اقتصادی مداوم یکی از کشورهای شش گانه هدف جمهوری اسلامی ایران در زمینه توسعه مناسبات اقتصادی با قاره آفریقا بشمار می رود. به همین دلیل این کشور به عنوان دومین مقصد محصولات زیستی دانش بنیان ایرانی انتخاب شده است.













































